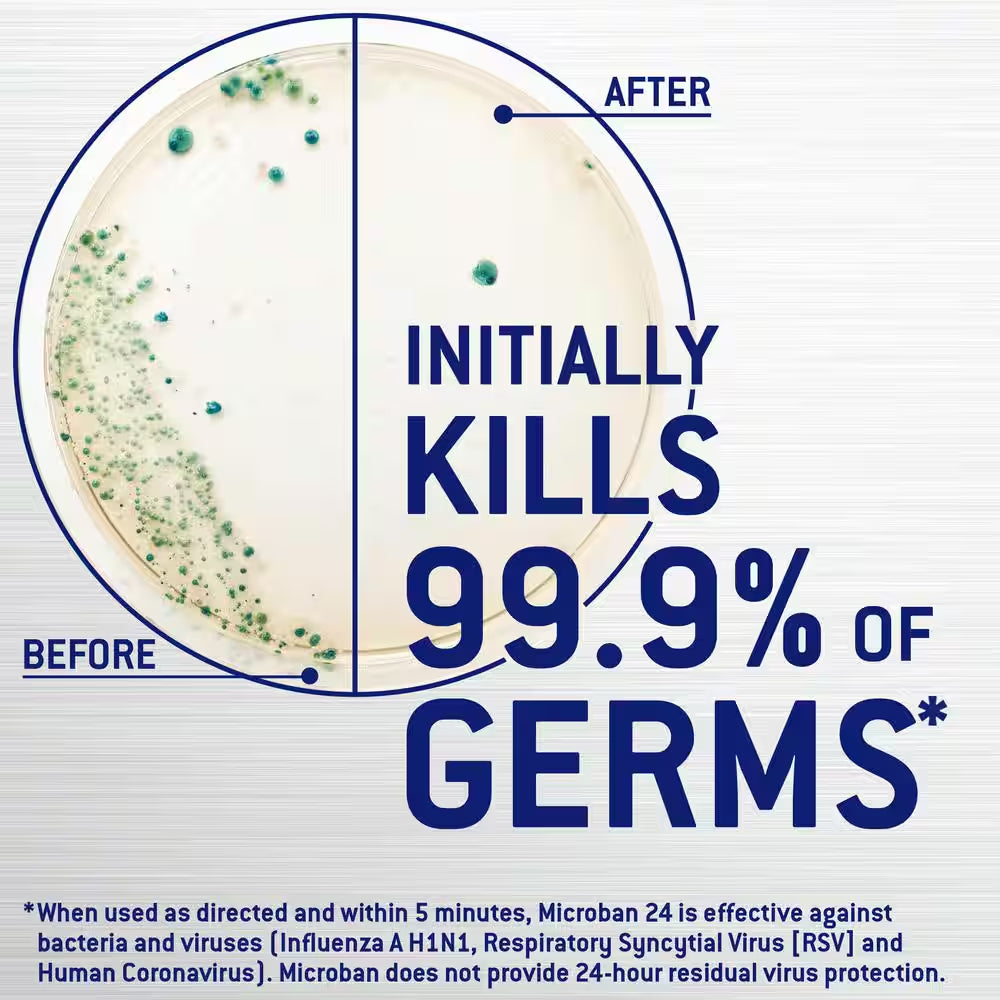

1
/
of
10
Opal And Ring Queen
32 Oz. Fresh Scent 24 Hour All Purpose Cleaner Spray
32 Oz. Fresh Scent 24 Hour All Purpose Cleaner Spray
Regular price
$8.45 USD
Regular price
$0.00 USD
Sale price
$8.45 USD
Quantity
Couldn't load pickup availability
- Microban provides 24-hour sanitization against bacteria
- Kills 99.9% of bacteria in five minutes and stays for 24 hours
- Microban spray cleans and sanitizes in one step
Microban 24-hour Multi-Purpose Cleaning Spray keeps killing 99.9% of bacteria for up to 24-hours, even after multiple touches, to support a clean and healthy home. This all-purpose sanitizing cleaner is great for every day messes and is suitable for use on all different types of non-food contact hard surfaces, like garbage cans, bathroom sinks, cabinets, etc. Use this multi-purpose spray for an efficient clean. Use around the home and on other high touch areas. This powerful formula penetrates soap scum and greasy soils while reducing odors. Let Microban protect you and your family from harmful germs for a healthy home. When used as directed Effective against S. aureus and E. Aerogenes +Effective against bacteria and viruses (Human Coronavirus, Influenza A H1N1, (RSV) Respiratory Syncytial Virus) ++ Effective against Aspergillus niger.
Share
Talk about your brand
Share information about your brand with your customers. Describe a product, make announcements, or welcome customers to your store.